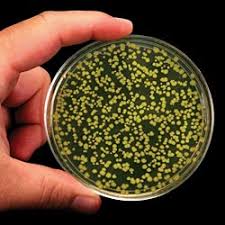

protozoan: one-celled animal-like organism with a nucleus.

cilia: short hair like part on the surfice of the cell.

sporonzoans: protozoans that reproduce by forming spores.

spores: special cells that develop into new organisim.

algea: plantlike protist.

multicellular: means that an organism has many different cells that do not certain jobs for the organism.

slime mold: fungus like protist that are consumers.

hyphae: network of threadlike structure most fungi are made up.

sporangium fungi: fungi that produce spores in sporangia.

sporangia: structure on the tips of hyphae that make spores.

club fungi :fungi with club-shaped parts that produce spores.

sac fungi:produce spores in saclike structures.

budding: reproduction in with small part of the parent grows into a new organism.

mutualism: arrangement in wich both organism are benefit.
lichen: a fungus and an organism with chlorophyll living thogether.

cilia: short hair like part on the surfice of the cell.
sporonzoans: protozoans that reproduce by forming spores.
spores: special cells that develop into new organisim.
algea: plantlike protist.
multicellular: means that an organism has many different cells that do not certain jobs for the organism.
slime mold: fungus like protist that are consumers.
hyphae: network of threadlike structure most fungi are made up.
sporangium fungi: fungi that produce spores in sporangia.
sporangia: structure on the tips of hyphae that make spores.
club fungi :fungi with club-shaped parts that produce spores.
sac fungi:produce spores in saclike structures.
budding: reproduction in with small part of the parent grows into a new organism.
mutualism: arrangement in wich both organism are benefit.
lichen: a fungus and an organism with chlorophyll living thogether.